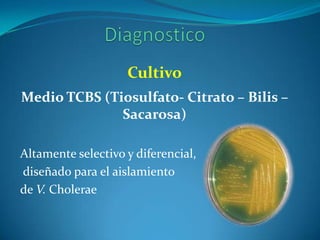
Cultivo
Medio TCBS (Tiosulfato- Citrato – Bilis –
              Sacarosa)

Altamente selectivo y diferencial,
diseñado para el aislamiento
de V. Cholerae

Este resumen describe la familia Vibrionaceae. Son bacilos Gram-negativos móviles con un flagelo polar que crecen entre 14-40°C y a pH entre 6.5-9. Incluyen el género Vibrio que causa el cólera. El cólera se transmite por agua o alimentos contaminados y causa diarrea acuosa severa que puede conducir a deshidratación y muerte si no se trata. El tratamiento incluye rehidratación oral o intravenosa y antibióticos como la tetraciclina